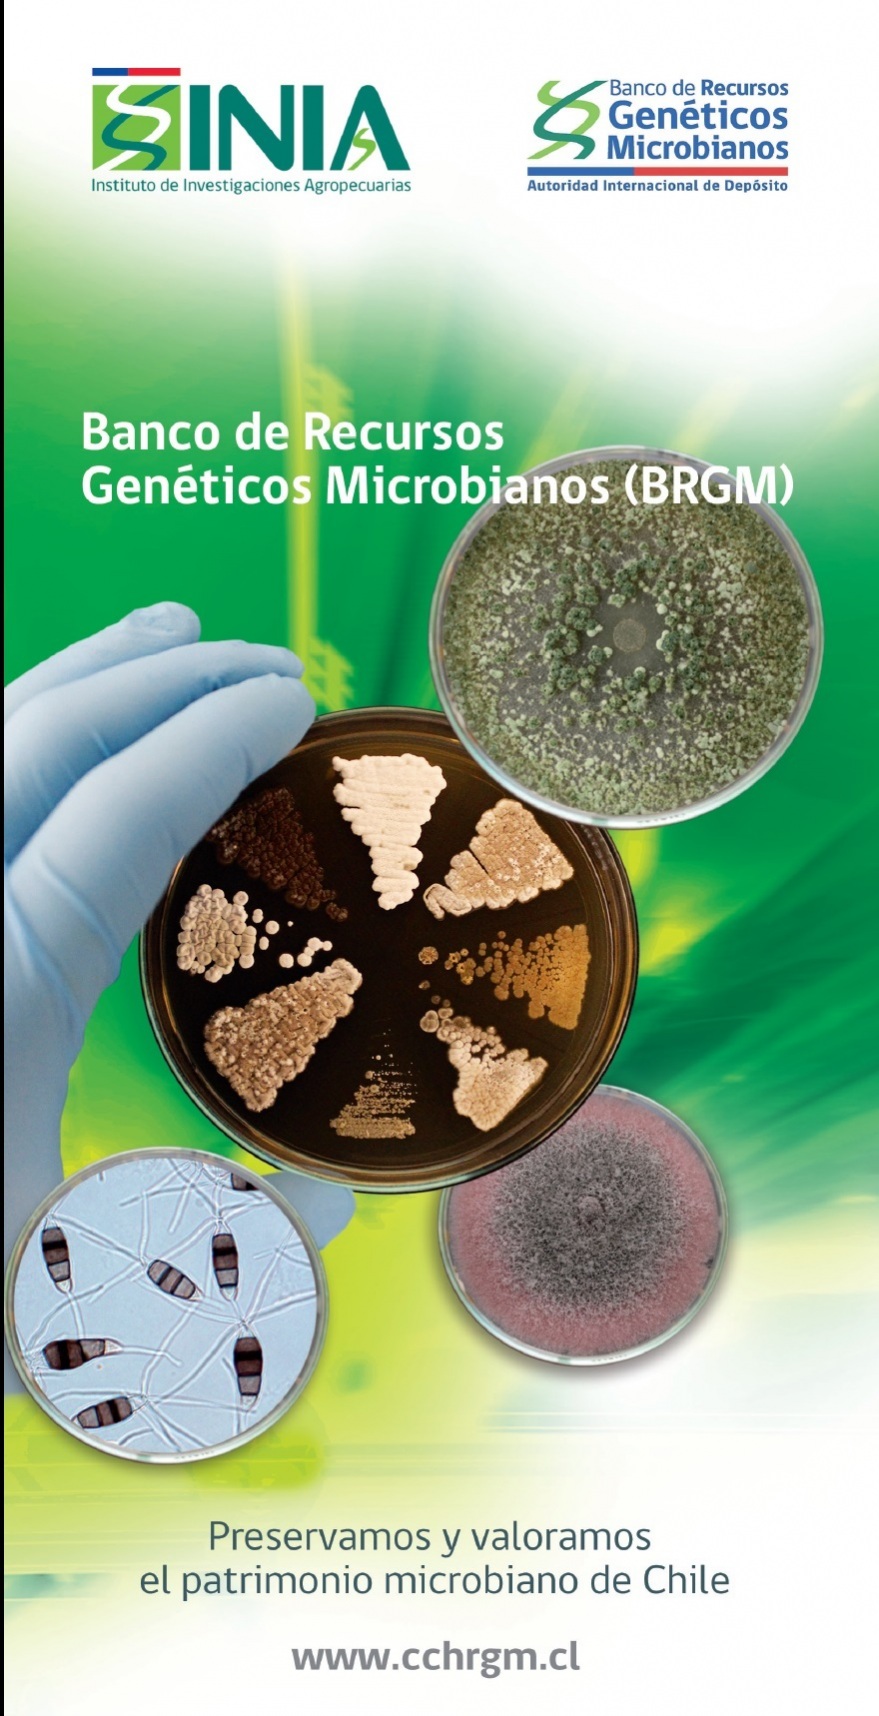

RED DE BANCOS DE GERMOPLASMA
Preservando y Valorando el Patrimonio fitogenético y Microbiano del País

Sobre nosotros
Los recursos genéticos se han transformado en materia prima fundamental para el desarrollo de investigaciones científico-tecnológicas y su valor en el desarrollo de bienes y servicios para la sociedad ha ido en aumento por los avances de la biotecnología. Por ello, su conservación y valoración constituye un recurso estratégico para el país.
Chile es un importante centro de la diversidad biológica en el mundo, tanto por el alto número de especies endémicas que posee, como por la alta diversidad intraespecífica de éstas. De las 4.655 especies de plantas nativas presentes en Chile, el 46% es endémica, es decir, sólo se encuentran en el territorio nacional. Éstas y otras características hacen de Chile un país muy importante como fuente de recursos genéticos vegetales.
INIA cuenta con una Red de Bancos de Germoplasma donde conserva alrededor de 33.000 accesiones de especies vegetales cultivadas y nativas, además de 4.083 accesiones de microorganismos. De los recursos fitogenéticos, aproximadamente un 91% de las accesiones corresponde a especies cultivadas (51% cereales, 28% leguminosas, 3% hortalizas, 3% forrajeras y 6% a otras especies, entre las que se incluye papas) y un 9% a especies nativas. No obstante, esta última colección es importante, ya que representa el 27% de la flora nativa chilena. En tanto, la colección pública de microorganismos del INIA está conformada principalmente por hongos y bacterias. De éstos, más del 80% tiene potencial para el desarrollo de bioinsumos de impacto en el sector agroalimentario. Del total de la colección, el 61% corresponde a hongos entomopatógenos, 23% a hongos fitopatógenos, 10% a hongos micopatógenos, 3% a hongos nematófagos, 2% a endófitos y 1% a bacterias.
ACTIVIDADES ANTERIORES
REVISA NUESTRA REDES SOCIALES
Documentos técnicos y colaboraciones
Próximas Actividades
nuestra misión
Fortalecer y modernizar el sistema de gestión integral de los Recursos Fitogenéticos y Microbianos, integrados a la Red de Bancos de INIA, para alcanzar niveles óptimos de conservación, de acuerdo a las necesidades del país y estándares internacionales, promoviendo el acceso y el intercambio equitativo para su valoración y uso.
Rodrígo Díaz. Encargado Documentación, Informática y Solicitudes, Red de Bancos de Germoplasma.
Britt Wallberg. Encargada Banco Base de Semillas
Carolina Pañitrur. Coordinadora Técnica de Soberanía Alimentaria, Encargada Banco Base.
Erika Salazar. Encargada Banco Activo La Platina.
Gerardo Tapia. Encargado Banco Activo Quilamapu.
Pedro Montesano. Encargado Banco Activo Carillanca.
Sandra Alba. Encargada Banco de Papas La Pampa.
Jean F. Castro. Encargado Banco Microbiano.
ACTIVIDADES ANTERIORES
En el marco del aniversario de los 30 años de Bancos de Germoplasma de INIA, se realizó el Serminario Internacional "La Importancia de los Recursos Genéticos para la Alimentación en Tiempos de Crisis", el día 6 de octubre de 2020.
También se realizaron tres Webinar durante el mes de octubre:
- 13 de octubre WEBINAR INIA: Red de Bancos De Germoplasma y su Importancia Estratégica en la Preservación de la Biodiversidad
- 20 de octubre WEBINAR INIA: Plantas Nativas y su Potencial Alimentario.
- 27 de octubre WEBINAR INIA: Cultivos Tradicionales y Pequeña Agricultura